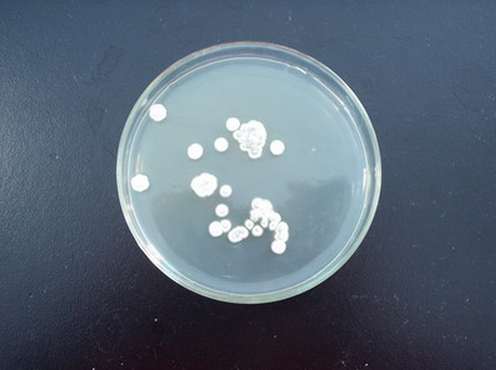
白色链霉菌

青色链霉菌

链霉菌
图片尺寸606x464
放线菌:主要分布在链霉菌属(streptomyces) 藻类:主要分布在小球藻属
图片尺寸1080x810
褐色链霉菌
图片尺寸250x200
链霉菌及其主要抗生素.ppt
图片尺寸1152x864
实验三-放线菌形态结构的观察2012.ppt
图片尺寸1152x864
产抗菌素的放线菌 a:卡特利链霉菌 b:弗氏
图片尺寸1080x810
白色链霉菌
图片尺寸496x370
灰色链霉菌产链霉素汇报,ppt
图片尺寸1080x810
三维演示乳酸菌的3d渲染插图细菌链霉菌在琼脂平板上邪恶的细菌金黄色
图片尺寸612x408
活性炭 技术问答 > 正文 1944年瓦克斯曼从链霉菌的培养液中提取了
图片尺寸600x450
新时代奋斗者 | 随性"上海爷叔" 实现"人造生命"重大突破
图片尺寸600x399
唤醒沉默的基因我国科学家找到揭秘微生物生命暗物质
图片尺寸760x506
地球上的一些细菌或许可以进一步拓展人类边界
图片尺寸700x392
枯草·细黄链霉菌-战线-万邦作物有效活菌数≥2.
图片尺寸550x866
除此之外,链霉菌是从灰色链丝菌中提取出来的,包括我国诺贝尔医学奖
图片尺寸600x350
浏阳霉素是由灰色链霉菌浏阳变种所产生的一种具有大环内酯结构的
图片尺寸640x449
微生物学报杂志社
图片尺寸293x392
绿恒丰全水溶细黄链霉菌叶面肥流胶青枯细菌性角斑叶面微生物菌肥
图片尺寸800x800
喜百农细无踪 细黄链霉菌番茄草莓青枯病黄瓜角斑病***病害广谱型杀菌
图片尺寸750x750
泰乐菌素
图片尺寸906x632


















(1).png)